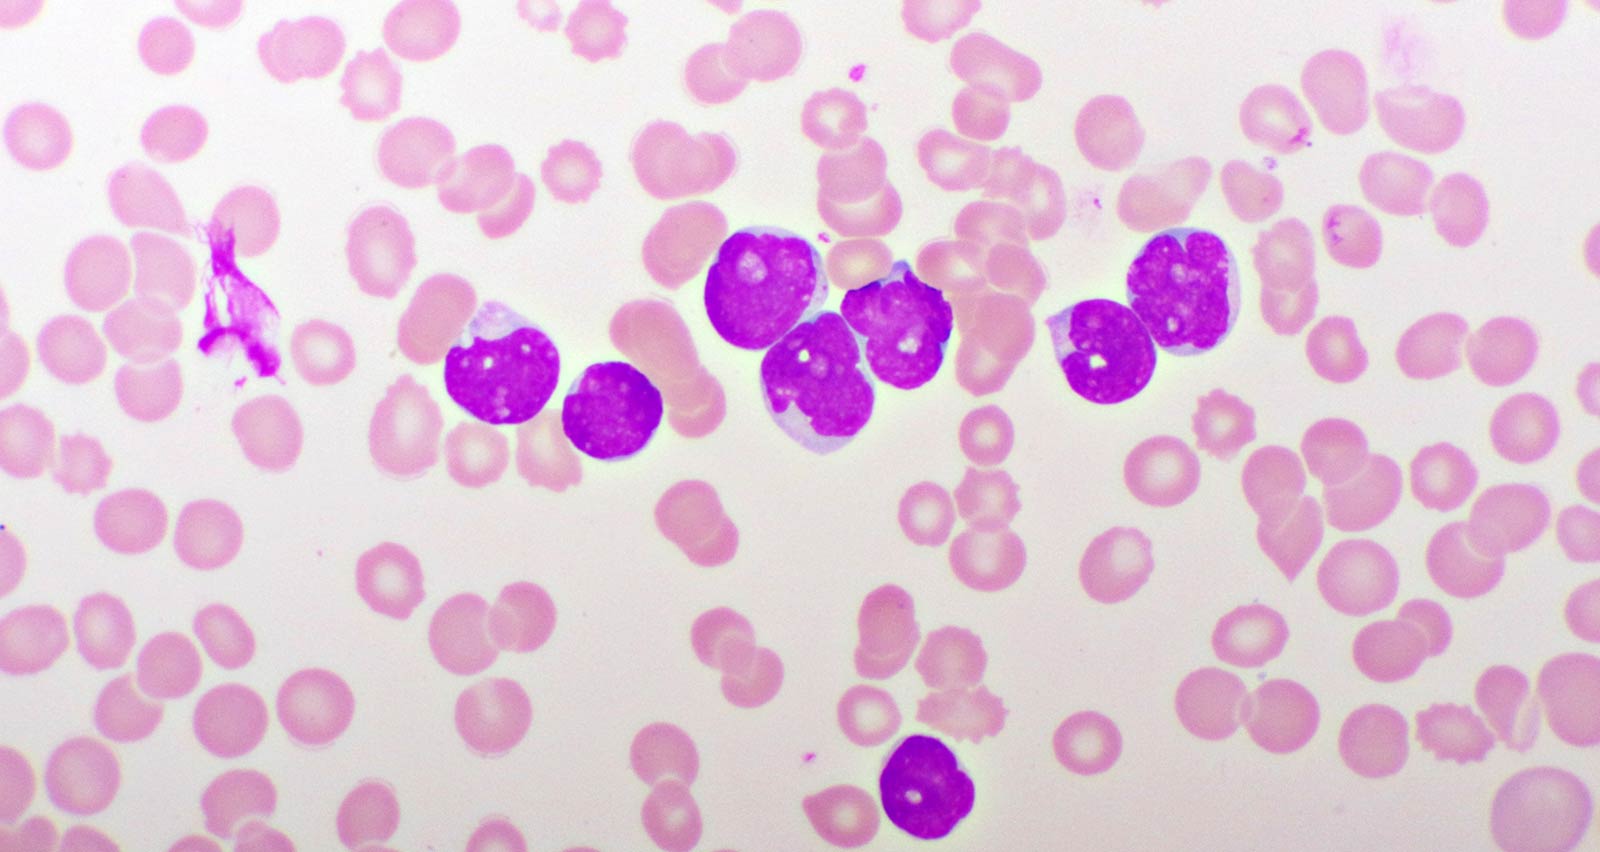
Microscopic picture of acute lymphocytic leukemia

What Is Acute Lymphoblastic Leukemia (ALL)?
Leukemias are cancers that start in cells that would normally develop into different types of healthy blood cells. Acute lymphoblastic leukemia (ALL), also known as acute lymphocytic leukemia, is a type of acute leukemia. Acute types of leukemia typically progress quickly if not treated. Although ALL is the most common leukemia to affect children, adults also get the disease.
ALL causes the bone marrow to rapidly produce abnormal lymphocytes, which are a type of white blood cell that normally helps the body fight infection. Not only are the abnormal lymphocytes found in people with ALL unable to fight infection effectively, they crowd out healthy cells and spread to other parts of the body, including the brain and spinal cord.
Your health is important. Get expert care.
Offering in-person, video and telephone visits. Call 216-844-3951 today to see which option is right for you.
Learn more about virtual visitWhat Causes Acute Lymphoblastic Leukemia?
ALL occurs due to changes in the genetic material (DNA) in bone marrow cells. Experts don’t yet understand the exact causes of these genetic changes. However, certain risk factors are associated with the disease, including:
- Sex: Men have a higher risk of ALL than women.
- Race: White people are at a higher risk than other races.
- Chemical exposure: Contact with certain chemicals is linked with ALL and other types of leukemia. For example, exposure to benzene may raise person’s risk for getting ALL.
- Radiation exposure: Exposure to high doses of radiation increases a person risk for ALL and other leukemias.
- Rare congenital diseases: Having Down syndrome or certain genetic disorders raises the risk of ALL.
Signs and Symptoms of Acute Lymphoblastic Leukemia
Signs and symptoms of adult ALL include:
- Feeling tired and/or weak
- Fever or night sweats
- Easy bruising or bleeding
- Petechiae (a rash that appears as tiny red spots on the skin caused by bleeding underneath the skin)
- Shortness of breath
- Pain in the bones or stomach
- Pain or feeling of fullness below the ribs
- Weight loss or loss of appetite
- Swollen, usually painless lymph nodes in the neck, underarms, stomach or groin
- Frequent infections
Note that other cancers and illnesses can cause these symptoms. Make sure to tell your doctor about any symptoms of disease you have.
How Is Acute Lymphoblastic Leukemia Diagnosed?
As an acute type of leukemia, ALL can progress quickly. An accurate diagnosis and treatment plan are essential.
Procedures and tests used to diagnose adult ALL include:
- Blood tests: A complete blood count (CBC) with differential test is used to measure the number of white blood cells, red blood cells and platelets in a blood sample. If a CBC test suggests leukemia, an ALL diagnosis can sometimes be confirmed with additional blood testing. Other times, diagnosis requires a bone marrow test.
- Bone marrow test (bone marrow aspiration and biopsy): During this test, a bone marrow sample is extracted from the hipbone or breastbone using a needle. Lab analysis will classify the blood cells in the marrow sample and determine if leukemia cells are present. This test also looks for changes in leukemia cells and shows whether those cells began from B lymphocytes or T lymphocytes, which is information that aids your doctor in developing your treatment plan.
- Imaging tests: Imaging tests such as an X-ray, a computerized tomography (CT) scan and ultrasound may be used to detect if cancer has spread to the brain and spinal cord or other areas of the body.
- Spinal fluid test: Also called a lumbar puncture test or a spinal tap, a spinal fluid test may be used to obtain a sample of spinal fluid (the fluid that surrounds the brain and spinal cord) to check for the presence of cancer cells.
How Is Acute Lymphoblastic Leukemia Treated?
Treatment for adult ALL usually takes place over a period of two to three years and is divided into three phases:
- Induction Therapy: During this phase, the goal is to kill most of the leukemia cells in the blood and bone marrow and restore the production of normal blood cells.
- Consolidation Therapy: Also known as post-remission therapy, this phase of treatment focuses on eliminating any remaining leukemia cells in the body.
- Maintenance Therapy: The goal of maintenance therapy it to prevent leukemia cells from regrowing. Treatments in this phase are generally given at much lower doses than the previous phases for a longer period of time.
During each phase of therapy, people with ALL may receive additional treatment to kill leukemia cells found in the central nervous system. This usually involves the injection of chemotherapy drugs directly into the fluid that surrounds the spinal cord.
Some combination of the following treatment approaches may be used:
- Chemotherapy
-
Chemotherapy uses drugs to kill cancer cells and is the primary treatment used in most ALL cases. Most often, chemotherapy drugs are injected directly into a vein, a muscle or under the skin, or else taken orally. By entering the bloodstream, the drugs can reach leukemia cells throughout the body. Chemotherapy is often used as an induction therapy for adults with ALL. It is also frequently used in the consolidation and maintenance phases.
- Targeted Therapy
-
Targeted therapy is a treatment method that uses drugs or other substances to identify and attack specific cancer cells. In general, targeted therapies cause less harm to normal cells than chemotherapy or radiation therapy. A patient’s leukemia cells can be tested to identify a targeted therapy. Targeted therapy can be used alone or in combination with chemotherapy during all three phases of ALL treatment.
- Radiation Therapy
-
Radiation therapy uses high-powered beams, such as X-rays or protons, to destroy cancer cells. Radiation therapy can be useful in ALL patients if the cancer cells have spread to the central nervous system.
- Bone Marrow Transplant
-
A bone marrow transplant, also known as a stem cell transplant, may be used during consolidation therapy and to treat relapses. The procedure replaces abnormal bone marrow with marrow from a healthy donor. Bone marrow transplants are performed after high doses of chemotherapy or radiation are used to destroy leukemia-producing bone marrow.
The Stem Cell Transplant Program at UH Seidman Cancer Center has provided advanced bone marrow and cord blood transplant services for more than 45 years. Since the program’s inception, we’ve performed over 3,500 stem cell transplants.
- Immunotherapy
-
Immunotherapy is a newer approach to treating cancer that harnesses the body’s natural defenses to fight the disease. For example, a specialized treatment called chimeric antigen receptor (CAR T) cell therapy alters the patient’s T cells (a type of immune system cell) so they will attack certain proteins on the surface of cancer cells, including those in ALL patients. In ALL treatment, CAR T can be used in consolidation therapy and for treating relapses.
UH Seidman Cancer Center is one of the few academic medical centers in the country to produce CAR T-cell therapy and other cell-based immunotherapies. On-site production allows us to make cell-based therapies more quickly and at a lower cost than what is available commercially.
Acute Lymphoblastic Leukemia Prognosis
Over the last few decades, medical advances have improved cure rates and survival for adults and children with ALL. Today, nearly 90 percent of adults diagnosed with ALL achieve a complete remission, meaning leukemia cells are no longer seen in the bone marrow under a microscope. However, despite the high remission rates, ALL relapses are common in adults. Survival rates for adult patients are approximately 20 to 40 percent. Nevertheless, survival rates vary significantly depending on other factors such as the subtype of ALL, the presence of specific mutations in the patient’s leukemia cells, the patient’s age and their general health.

Clinical Trials Available for Acute Lymphoblastic Leukemia and Other Types of Leukemia
Access to innovative treatments, including leukemia-specific clinical trials with targeted therapies, gives patients more treatment options. We offer new therapies that are safer, more tolerable and more targeted to minimize side effects. Our physicians are the principal investigators for many of these cancer clinical trials, offering hope to both newly diagnosed leukemia patients and those who have relapsed.
Clinical Trials for Leukemia
Giving to UH Seidman
Make a gift today to support leukemia research and patient care at UH Seidman Cancer Center.
Ways To Give

